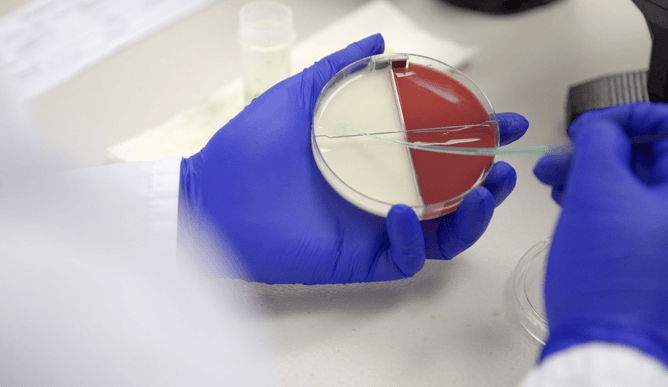
Credit: DairySmart

We now have a smarter way of finding out what bacteria is lurking on your farm and causing mastitis.
A wet spring won’t be helping how many cases of mastitis you’re seeing, which impact both production and upcoming reproduction, as well as being costly. We can help diagnose what bacteria is causing mastitis in your cows using our new Jupiter testing machines from DairySmart, now in the Winton and Gore clinics.
With unique culture plates, these advanced machines test milk samples for different pathogens and deliver accurate results, usually within 24 hours. We’re excited to be able to offer this easy and affordable testing process, as understanding which bacteria is causing your mastitis cases will enable the right treatment to be prescribed straight away.
Plus, it will help you figure out what you can do to prevent more cases, depending on what bug it is. This new testing method is also capable of diagnosing what bacteria is affecting cows with subclinical mastitis or high cell counts (which you might find after a herd test).
If you are interested in taking better control of mastitis on your farm, talk to your KeyVet about utilising DairySmart Jupiter testing.